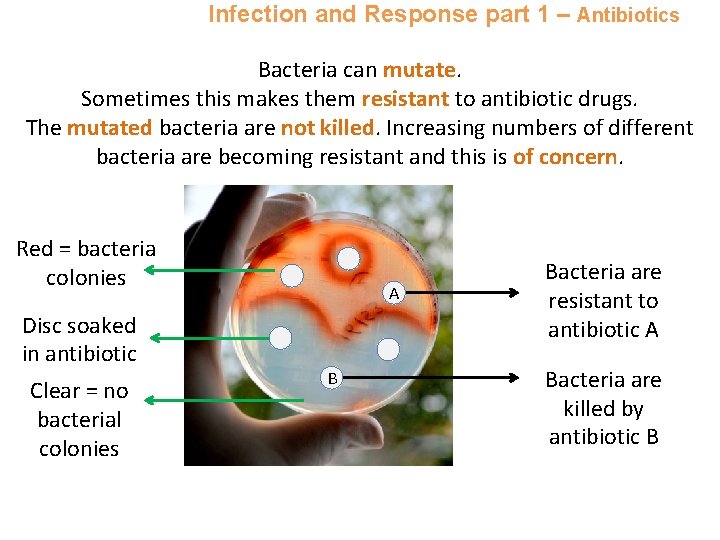
Infection and Response part 1 – Antibiotics Bacteria can mutate. Sometimes this makes them

Communicable diseases Communicable infectious diseases Viral diseases Bacterial

Communicable diseases • • • Communicable (infectious) diseases Viral diseases Bacterial diseases Fungal diseases Protist diseases Human defence systems Vaccination Antibiotics and painkillers Discovery and development of drugs Monoclonal Antibodies (Biology HT only) • • Producing monoclonal antibodies Uses of monoclonal antibodies Plant Disease (Biology only) • • Detection & identification of plant diseases Plant defence responses Overview Infection and Response

Infection and Response part 1 – Infectious diseases Pathogens are micro organisms that cause infectious disease. Pathogens may infect plants or animals and can be spread by direct contact, by water or by air. Pathogens depend on the host to provide the suitable conditions and nutrients that they need to grow and reproduce. Pathogens can be bacteria, viruses, fungi or protists. Viral diseases • Viruses may reproduce rapidly Bacterial diseases • Bacteria may reproduce rapidly • Viruses live and reproduce inside • Bacteria may produce toxins that damage tissues and make cells causing damage us feel ill

Infection and Response part 1 – Infectious diseases Pathogens may infect plants or animals and can be spread by direct contact (D), by water (W) or by air (A). A W D A D

Infection and Response part 1 – Viral diseases Examples of Viral Diseases Measles • Symptoms of fever and a red skin rash • Can be fatal if complications occur • Spread by inhaling droplets containing the virus from sneezes and coughs • It is controlled by vaccinating young children HIV • Initially causes a flu-like illness and spread by sexual contact or exchange of body fluids such as blood when drug users share needles • Unless HIV is successfully controlled with antiretroviral drugs, the virus will attack the body’s immune cells • Late stage HIV or AIDS occurs when the body’s immune system can no longer deal with other infections or cancers Tobacco Mosaic virus • Common plant virus which enters through a damaged epidermis • Seen as a distinct mosaic discolouration pattern on the leaves • Affects growth as photosynthesis cannot occur as efficiently • Control by removing affected leaves and destroying pests which caused initial epidermal damage

Infection and Response part 1 – Bacterial diseases Examples of Bacterial Diseases Salmonella • Salmonella food poisoning is spread by bacteria ingested in food or on food prepared in unhygienic conditions. • Bacteria secrete toxins and cause symptoms including fever, abdominal cramps, diarrhoea and vomiting. • In the UK, poultry are vaccinated against salmonella to control the spread of the disease. Gonorrhoea • Sexually transmitted disease (STD) caused by bacteria. • Causes a thick yellow or green discharge from the penis or vagina and pain when urinating. • Can be controlled with antibiotics or barrier methods of contraception such as a condom. • Easily treated with the antibiotic penicillin until many resistant bacterial strains were found.

Infection and Response part 1 – Fungal and Protist diseases Example of a Fungal Disease Rose Black Spot § Purple or black spots develop on leaves § Leaves often turn yellow and drop off § Photosynthesis is reduced. Growth is affected as a result § Fungal spores spread by wind or water § Treat by removing infected leaves and burning them § Spray with fungicide (a pesticide which is used to kill fungus) Example of a Protist Disease Malaria § The malaria causing protist is spread by mosquitoes feeding on infected blood and then biting a human § Mosquitoes are vectors as they pass on malaria but do not suffer themselves § Symptoms include recurrent fever and malaria can be fatal § Control the spread by preventing mosquitoes breeding and use mosquito nets to avoid being bitten

Infection and Response part 1 – Types of diseases Disease Malaria Symptom Recurrent fever Method of transmission Control spread of disease by: Caused by: By a vector from an infected person Preventing breeding of mosquitoes or use of a net to prevent being bitten Protist Tobacco Mosaic Virus Mosaic pattern on leaves Enters via wounds in epidermis caused by pests Remove infected leaves and control pests which are damaging leaves Virus Measles Fever Red skin rash Droplet infection from sneezes and coughs Child Vaccination Virus Gonorrhoea Green discharge from penis or vagina Direct sexual contact or body fluids Use of a condom and treat infected person with antibiotics Bacteria Rose Black Spot Purple black spots on leaves Spores carried via wind or water Remove infected leaves and spray with pesticide Fungus Salmonella Fever, cramp, vomiting, diarrhoea Food prepared in unhygienic conditions or not cooked properly Improve food hygiene, wash hands, vaccinate poultry, cook food thoroughly Bacteria

Infection and Response part 1 – Human Defence Systems n o s e Nasal hairs, sticky mucus and cilia prevent pathogens entering through the nostrils. s t o m a c h Stomach acid (p. H 1) kills most ingested pathogens trachea bronchus The human body has several non specific ways of defending itself from pathogens getting in. video Respiratory system is lined with mucus to trap dust and pathogens. Cilia move the mucus upwards to be swallowed. s k i n Hard to penetrate waterproof barrier. Glands secrete oil which kill microbes.

Infection and Response part 1 – Human Defence Systems Sometimes pathogens gain entry to the body. The immune system takes over to destroy them. The white blood cells are part of the immune system. Pathogens are identified by white blood cells because they have different surface proteins. We call these surface proteins antigens. White blood cells act in 3 ways to defend the body: 1. White blood cells (called phagocytes) engulf the pathogens and digest them. This is called phagocytosis. Video phagocytes 2. White blood cells (called lymphocytes) identify the antigen on the pathogen. They make specific antibodies to destroy the pathogens. This can take time and so an infection may occur. If a person is infected again by the same pathogen, the white blood cells make the antibodies much faster. Video lymphocytes 3. Bacteria may produce toxin (poison). White blood cells release specific antitoxins to neutralise the effect of the toxin.

Infection and Response part 1 – Vaccination Communicable diseases can be dangerous leading to epidemics or pandemics. Vaccination can be used to enhance the immune system to reduce the chances of this happening. A vaccine contains a small amount of dead or inactive form of the pathogen that can be introduced into the body. Lymphocyte pathogen White blood cells detect pathogens in the vaccine. Antibodies are released into the blood. Pathogens are destroyed by antibodies.

Infection and Response part 1 – Vaccination If the body becomes re-infected with the same pathogen the white blood cells are prepared. The white blood cells can respond much more quickly and make more of the right type of antibodies much more quickly. White blood cells detect pathogens. Antibodies are made and released into the blood much faster and in larger amounts. Pathogens are destroyed by the antibodies much faster. This means that the person is unlikely to suffer the symptoms of the harmful disease. Infection has been prevented by enhancing the immune system.

Infection and Response part 1 – Antibiotics An antibiotic is a drug that helps to cure a bacterial disease by killing the infective bacteria inside the body. Different bacterial infections need a different antibiotic. Penicillin is a well known antibiotic medicine. Antibiotics cannot be used to treat viral pathogens. Using antibiotics has greatly reduced deaths. It is difficult to develop drugs to kill viruses without harming body tissues because viruses live and reproduce inside cells.
Infection and Response part 1 – Antibiotics Bacteria can mutate. Sometimes this makes them resistant to antibiotic drugs. The mutated bacteria are not killed. Increasing numbers of different bacteria are becoming resistant and this is of concern. A Red = bacteria colonies Disc soaked in antibiotic Clear = no bacterial colonies A B Bacteria are resistant to antibiotic A Bacteria are killed by antibiotic B

Infection and Response part 1 –– Painkillers A doctor will not prescribe antibiotics for a viral infection as they do not work. Antibiotics can only be used for bacterial infections Painkillers, steroids or anti inflammatory medicines can be used to relieve the symptoms of viral infections. Symptoms may include: fever, muscle ache, headache or a runny nose. Painkillers do not kill pathogens.

Infection and Response part 2 – Discovery & drug development Aspirin is a painkiller and antiinflammatory drug. This was first found in willow bark. Traditionally drugs were extracted from plants and micro-organisms. video Foxglove plants have been a source of the drug digitalis which acts on the heart. Alexander Fleming is famous for discovering Penicillium mould. Fleming noticed the fungus on unwashed equipment and went on to discover its antibiotic properties.

Infection and Response part 2 – Development of drugs Most new drugs are developed and synthesised (made) in a laboratory by chemists in the pharmaceutical industry. The initial chemical may have been sourced from a plant. New drugs must be tested and trialled to check: ü Efficacy - that the drugs work ü Toxicity - that the drug is not poisonous ü Dose - the most suitable amount to take Preclinical tests must be carried out before humans are allowed to take the drug. These preclinical tests are done on cells, tissue samples and live animals.

Infection and Response part 2 – Drug development If successful the new drug will proceed to a clinical trial. The stages of a clinical trial are: • Healthy volunteers try small doses of the drug to check it is safe Stage 1 and has no side effects • A small number of patients try the drug at a low dose to see if it Stage 2 works • A larger number of patients take the new drug and different doses Stage 3 are trialled to find the optimum dose • A double blind trial will occur to see how effective the new drug is. Stage 4 The patients are divided into groups video

Infection and Response part 2 – Drug development A double blind trial is carried out on patients who have the disease to make sure that it is actually the drug which is having an effect on the patients and not anything else. The details of everyone taking part in the trial is entered into a computer database. The computer groups people randomly. Each person receives a unique code and they receive the medicine which is labelled with the matching code. No-one knows who is receiving the real drug or a placebo until the end of the trial. The placebo is often the drug the patient was originally taking so they still receive medical treatment.

Infection and Response part 2 – Monoclonal antibodies (Biology HT) Monoclonal antibodies are identical copies of one type of antibody produced in a laboratory. How to produce monoclonal antibodies: 1. A mouse is injected with a pathogen 2. White blood cells called lymphocytes produce antibodies 3. Lymphocytes are removed from the mouse and fused with rapidly dividing mouse tumour cells 4. The new cells are called hybridomas. 5. The hybridomas divide rapidly and release lots of antibodies which are then collected. Mono = one

Infection and Response part 2 – Monoclonal antibodies (Biology HT) Monoclonal antibodies are specific to one binding site on the antigen. This means that we can use monoclonal antibodies to target a specific chemical or specific cells in the body. During pregnancy, a hormone called HCG is released into the blood. Monoclonal antibodies can detect the presence of this chemical at low levels and are used in pregnancy testing kits.

Infection and Response part 2 – Monoclonal antibodies (Biology HT) Monoclonal antibodies are also used in treating some cancers. ØThe monoclonal antibodies are specific to the antigen on the cancer cells. ØA chemical which stops cells dividing can be bound to the monoclonal antibodies. ØThe patient is given the monoclonal antibodies and they attach to receptors on the cancer cells. ØThe chemical stops the cancer cells growing and dividing.

Infection and Response part 2 – Monoclonal antibodies (Biology HT) Monoclonal antibody research has raised some concerns about their ethical use. Mice are injected with pathogens and so they will experience the disease symptoms. Monoclonal antibodies have been successful in treating some cancers and diabetes. But there have been deaths when used to treat patients with multiple sclerosis (MS). Mice provide antibody producing cells and tumour cells. Mice are induced with cancer to get the tumour cells. Herceptin is used for breast cancer. It is not toxic and is specific to breast cancer cells so few side effects. But it is costly.

Infection and Response part 3 – Plant disease (Biology HT) Plants suffer from a range of infections caused by pathogens or insect pests. We can detect a plant is diseased by these signs: Unusual growths Spots or discoloured leaves Malformed leaves or stems

Infection and Response part 3 – Plant disease (Biology HT) If a plant disease is suspected then it may be identified using: The presence of pests üGardening manuals üGardening websites Stunted growth Areas of decay (rot) ü Test kits containing monoclonal antibodies üTaking infected plants to a laboratory to identify the pathogen

Infection and Response part 3 – Plant disease (Biology HT) Healthy plants need mineral ions. Nitrate ions are needed in protein synthesis and hence growth. Horticulturists use knowledge about the effect of ion deficiencies to supply plants with optimum conditions. Nitrate ions = healthy growth Lack of nitrate = stunted growth Magnesium = healthy chlorophyll Lack of magnesium = chlorosis (yellowing of leaves due to lack of chlorophyll)

Infection and Response part 3 – Plant disease (biology only ) l ica ys Ph l ca ni ha ec M Antibacterial and poisonous chemicals are found in many plants like witch hazel. Plants have several ways of defending themselves from pathogens and to deter herbivores. Ch em ica l Thick waxy layers, tough cellulose cell walls and bark defend the plant from pathogen entry M ec ha ni ca l video Touch can make Mimosa leaves suddenly curl which frightens animals Thorns make plants painful to be eaten
- Slides: 26